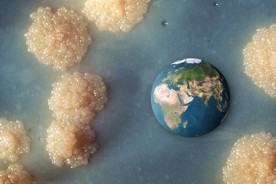

| ← Апрель 2012 → | ||||||
|
26
|
||||||
За последние 60 дней 60 выпусков (примерно раз день)
Сайт рассылки:
http://ufonews.su/
Открыта:
28-11-2000
Статистика
0 за неделю